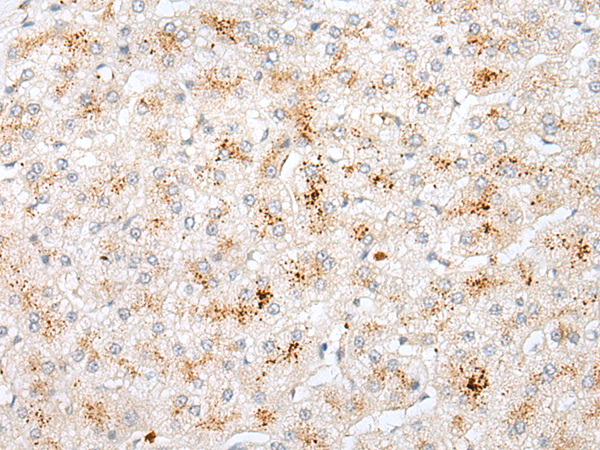

|
Background: |
The product of this gene is a member of the GCK group III family of kinases, which are a subset of the Ste20-like kinases. The encoded protein contains an amino-terminal kinase domain, and a carboxy-terminal regulatory domain that mediates homodimerization. The protein kinase localizes to the Golgi apparatus and is specifically activated by binding to the Golgi matrix protein GM130. It is also cleaved by caspase-3 in vitro, and may function in the apoptotic pathway. Several alternatively spliced transcript variants of this gene have been described, but the full-length nature of some of these variants has not been determined. |
|
Applications: |
ELISA, IHC |
|
Name of antibody: |
STK26 |
|
Immunogen: |
Synthetic peptide of human STK26 |
|
Full name: |
serine/threonine protein kinase 26 |
|
Synonyms: |
MASK; MST4 |
|
SwissProt: |
Q9P289 |
|
ELISA Recommended dilution: |
5000-10000 |
|
IHC positive control: |
Human liver cancer |
|
IHC Recommend dilution: |
10-50 |
購物車
購物車 幫助
幫助
 021-54845833/15800441009
021-54845833/15800441009
